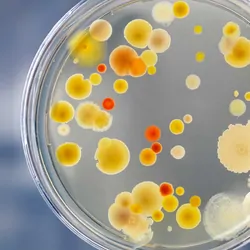
Bacteria growin on a petri dish being held by a gloved hand

Content by Cornell University
Filter by
AllArticlesAudioEbooksEventsInfographicsNewsProductsSurveysDocumentsVideosVirtual EventsWebinars
A proof of principle study uses a bacteria to help extract rare earth elements in a more environmentally friendly way
| 2 min read























